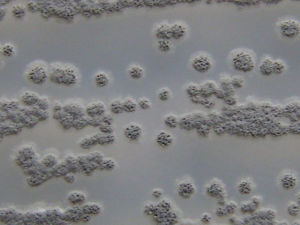
勞倫鏈黴菌

基本信息
中文學名勞倫鏈黴菌
拉丁學名Streptomyceslaurentii
參考文獻J.Antibiotics30:639-643,1977.
形態特徵
孢子絲直、彎曲、鉤狀至初旋1圈。孢子卵圓形,表面光滑。
鏈黴菌
鏈黴菌代表菌株:ATCC31、255,分離自美國勞倫斯城土樣。
簡介
無機鹽澱粉瓊脂(ISP):氣絲生孢子好,淺橙粉色。基絲反面紅橙色。無可溶色素。酵母精麥芽精瓊脂(ISP):氣絲白色,生孢子後微粉色。基絲反面褐橙色。可溶色素淺粉紅色。燕麥粉瓊脂:氣絲灰黃粉色、污粉色,生孢子好。基絲反面無色。無可溶色素。不產生類黑色素和酪氨酸酶。細胞壁水解液含LL—二氨基庚二酸。利用葡萄糖、木糖、蔗糖以及半乳糖、乳糖、蜜二糖;不利用阿拉伯糖、果糖、鼠李糖、棉子糖、肌醇、甘露醇以及海藻糖、山梨醇。產生硫鏈菌素(thiostrepton),抑制革蘭氏陽性細菌、分枝桿菌。盤點世界上的微生物(九)
| 微生物是包括細菌、病毒、真菌以及一些小型的原生動物、顯微藻類等在內的一大類生物群體,它個體微小,卻與人類生活關係密切。涵蓋了有益有害的眾多種類,廣泛涉及健康、食品、醫藥、工農業、環保等諸多領域。 |
